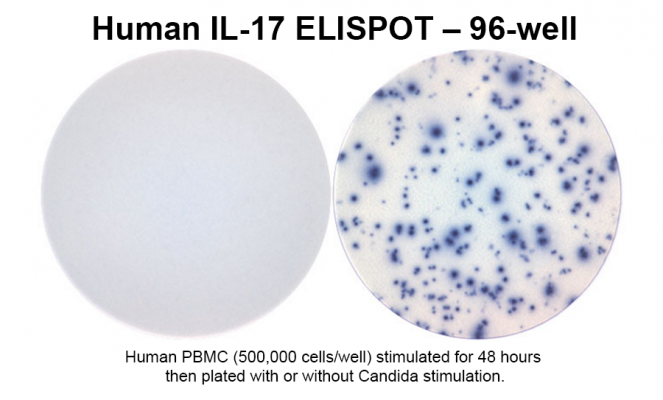

Human IL-17 Single-Color ELISPOT

Protocol Request

Inquire about Kits and Components
Pricing is for US and Canada only and does not include shipping.
All others, contact the distributor in your region.
A flat rate for shipping will be applied to all orders. To use your company's FedEx account number, please contact us before placing your order.
Details
CTL offers the ONLY COMPLETE kit that comes with everything you need – ALL FROM ONE SOURCE! This ImmunoSpot® kit includes serum-free assay media, diluents, antibodies, colorimetric detection system and an optional pre-coated PVDF-membrane plate.
Related Products & Services
Documents
-
 Four-color T and B cell ELISPOT for simultaneous detection of analytes (266.46 KB)
Four-color T and B cell ELISPOT for simultaneous detection of analytes (266.46 KB)
-
 96-well-counting (245.32 KB)
96-well-counting (245.32 KB)
-
 ImmunoSpot T Cell Kits Brochure (359.99 KB)
ImmunoSpot T Cell Kits Brochure (359.99 KB)
-
 ELISPOT assays provide reproducible results among different laboratories for T cell immune monitoring — even in hands of ELISPOT-inexperienced investigators (312.75 KB)
ELISPOT assays provide reproducible results among different laboratories for T cell immune monitoring — even in hands of ELISPOT-inexperienced investigators (312.75 KB)
-
 High reproducibility of ELISPOT counts from nine different laboratories (534.74 KB)
High reproducibility of ELISPOT counts from nine different laboratories (534.74 KB)
-
 ELISPOT assays in 384-well format: Up to 30 data points with one million cells (374.30 KB)
ELISPOT assays in 384-well format: Up to 30 data points with one million cells (374.30 KB)
-
 Resting of cryopreserved PBMC does not generally benefit the performance of antigen-specific T cell ELISPOT assays (701.83 KB)
Resting of cryopreserved PBMC does not generally benefit the performance of antigen-specific T cell ELISPOT assays (701.83 KB)
-
 Optimal thawing of cryopreserved peripheral blood mononuclear cells for use in high-throughput human immune monitoring studies (237.77 KB)
Optimal thawing of cryopreserved peripheral blood mononuclear cells for use in high-throughput human immune monitoring studies (237.77 KB)
-
 Neuroantigen-specific CD4 cells expressing IFN-γ, IL-2 and IL-3 in a mutually exclusive manner prevail in EAE (572.39 KB)
Neuroantigen-specific CD4 cells expressing IFN-γ, IL-2 and IL-3 in a mutually exclusive manner prevail in EAE (572.39 KB)
-
 Terms and Conditions (189.14 KB)
Terms and Conditions (189.14 KB)
Configure Human IL-17 Single-Color ELISPOT
|
|
|
|
|
|
|
|
|
|
|
|
|
|
|
|
|
|
|
|
|
|
|
|
|
|
|
|
|
OR